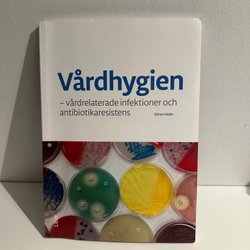

Sluttid16 dec. 19:57.
Pris:50 SEK,Eller Køb nu 60 SEK,.
Sluttid8 jan. 19:40.
Pris:108 SEK,Køb nu.
Sluttid8 jan. 19:40.
Pris:67 SEK,Køb nu.
Sluttid8 jan. 19:40.
Pris:135 SEK,Køb nu.
Sluttid8 jan. 19:39.
Pris:150 SEK,Køb nu.
Sluttid8 jan. 19:39.
Pris:150 SEK,Køb nu.
Sluttid8 jan. 16:18.
Pris:70 SEK,Køb nu.
Sluttid16 dec. 16:17.
Pris:40 SEK,Eller Køb nu 50 SEK,.
Sluttid8 jan. 15:02.
Pris:90 SEK,Køb nu.
Sluttid15 dec. 09:43.
Pris:199 SEK,Startpris.
Sluttid16 dec. 09:43.
Pris:199 SEK,Startpris.
Sluttid16 dec. 09:43.
Pris:99 SEK,Startpris.
Sluttid16 dec. 09:43.
Pris:99 SEK,Startpris.
Sluttid22 dec. 19:25.
Pris:35 SEK,Eller Køb nu 39 SEK,.
Sluttid20 dec. 17:42.
Pris:95 SEK,Startpris.
Sluttid20 dec. 18:41.
Pris:135 SEK,Eller Køb nu 150 SEK,.
Sluttid12 dec. 21:32.
Pris:24 SEK,Startpris.
Sluttid7 jan. 20:46.
Pris:132 SEK,Køb nu.
Sluttid11 dec. 20:22.
Pris:600 SEK,Eller Køb nu 990 SEK,.
Sluttid7 jan. 17:49.
Pris:350 SEK,Køb nu.
Sluttid7 jan. 17:45.
Pris:300 SEK,Køb nu.
Sluttid15 dec. 10:44.
Pris:40 SEK,Eller Køb nu 50 SEK,.
Sluttid10 dec. 23:05.
Pris:328 SEK,Startpris.
Sluttid14 dec. 20:19.
Pris:400 SEK,Startpris.
Sluttid14 dec. 18:42.
Pris:90 SEK,Eller Køb nu 270 SEK,.
Sluttid14 dec. 18:41.
Pris:50 SEK,Eller Køb nu 100 SEK,.
Sluttid14 dec. 18:09.
Pris:769 SEK,Startpris.
Sluttid14 dec. 18:00.
Pris:130 SEK,Startpris.
Sluttid11 dec. 13:57.
Pris:150 SEK,Startpris.
Sluttid11 dec. 13:31.
Pris:270 SEK,Startpris.
Sluttid13 dec. 09:43.
Pris:50 SEK,Eller Køb nu 69 SEK,.
Sluttid14 dec. 02:38.
Pris:80 SEK,Startpris.
Sluttid4 jan. 23:43.
Pris:250 SEK,Køb nu.
Sluttid12 dec. 17:56.
Pris:250 SEK,Eller Køb nu 299 SEK,.
Sluttid12 dec. 17:56.
Pris:250 SEK,Eller Køb nu 299 SEK,.
Sluttid12 dec. 17:56.
Pris:299 SEK,Eller Køb nu 320 SEK,.
Sluttid14 dec. 13:07.
Pris:99 SEK,Eller Køb nu 349 SEK,.
Sluttid14 dec. 13:07.
Pris:99 SEK,Eller Køb nu 299 SEK,.
Sluttid12 dec. 12:47.
Pris:159 SEK,Eller Køb nu 279 SEK,.
Sluttid3 jan. 23:25.
Pris:199 SEK,Køb nu.
Sluttid12 dec. 20:19.
Pris:30 SEK,Eller Køb nu 40 SEK,.
Sluttid11 dec. 20:34.
Pris:40 SEK,Eller Køb nu 45 SEK,.
Sluttid2 jan. 17:38.
Pris:149 SEK,Køb nu.
Sluttid2 jan. 16:52.
Pris:150 SEK,Køb nu.
Sluttid2 jan. 16:52.
Pris:150 SEK,Køb nu.
Sluttid12 dec. 21:57.
Pris:170 SEK,Startpris.
Sluttid13 dec. 18:54.
Pris:400 SEK,Startpris.
Sluttid14 dec. 11:30.
Pris:125 SEK,Eller Køb nu 150 SEK,.
Sluttid31 dec. 10:56.
Pris:360 SEK,Køb nu.
Sluttid14 dec. 21:15.
Pris:583 SEK,Eller Køb nu 619 SEK,.
Sluttid14 dec. 21:08.
Pris:323 SEK,Eller Køb nu 348 SEK,.
Sluttid14 dec. 17:49.
Pris:49 SEK,Eller Køb nu 55 SEK,.
Sluttid14 dec. 17:45.
Pris:35 SEK,Eller Køb nu 39 SEK,.